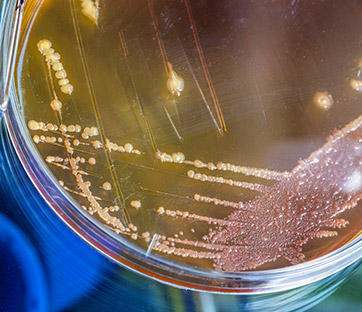

Polio, lebbra, tubercolosi: il rischio c’è ancora
Di malattie come colera, lebbra, tubercolosi e, ultima in ordine di tempo poliomielite, non si legge solo sui libri di storia ma si continua a discutere come di problemi sanitari in molti Paesi in via di sviluppo, non senza qualche episodio anche in Europa.
In Siria, dopo le prime segnalazioni a ottobre, sono saliti a 13 i casi di poliomielite, una malattia assente dal Paese dal 1999, in linea con la diminuzione dei malati a livello mondiale: dai 350.000 del 1988 ai 223 del 2012. “In realtà – afferma Dino Sgarabotto, responsabile del reparto di malattie infettive e tropicali dell’azienda ospedaliera di Padova – sapevamo che il virus circolava nelle acque del Nilo e in altri fiumi già da un anno e che quindi il rischio di contagio esisteva”. E infatti l’Oms sottolinea che il virus diffusosi in Siria è molto simile a quello trovato in campioni ambientali in Egitto lo scorso dicembre e in Pakistan e, da febbraio di quest’anno anche in Israele, in Cisgiordania e nella Striscia di Gaza. “La distribuzione della malattia – sottolinea Sgarabotto – segue quella delle guerre, dove le campagne di vaccinazione non riescono ad arrivare”. In Siria, tra il 2010 e il 2012, i tassi di vaccinazione contro la poliomielite erano diminuiti dal 91% al 68%. Ora, in risposta all’emergenza sanitaria delle ultime settimane, la reazione del governo è stata un’immediata campagna di vaccinazione su larga scala. Ed epidemiologi come Martin Eichner e Stefan O Brockmann su Lancet, non escludono che il contagio possa mettere in pericolo anche il nostro continente. Centinaia di migliaia di persone sono in fuga dalla Siria e cercano rifugio nei Paesi vicini: secondo i due medici in Europa i vaccini usati non renderebbero completamente immuni dalla malattia.
Ma quella della poliomielite non è l’unica fonte di preoccupazione per le autorità sanitarie che sono chiamate alla vigilanza anche nei Paesi in cui è ancora presente la lebbra. Complessivamente a livello mondiale nei primi mesi del 2012 furono individuati 232.876 nuovi casi. E anche in Europa, negli ultimi anni, i casi di lebbra non sono mancati. Secondo i dati dell’Organizzazione mondiale della sanità (Oms) i casi segnalati in Italia sono stati due nel 2007 e cinque nel 2010. Numeri più alti per altri Paesi: 63 in Spagna e 36 in Portogallo tra il 2007 e il 2010, contro i 42 del Regno Unito tra il 2007 e il 2012. Certo, come sottolinea l’Oms, oggi si tratta di una malattia di più facile diagnosi e trattamento e in molti dei Paesi in cui è endemica gli ospedali si stanno attrezzando per disporre di servizi specifici per la cura. Rimane il fatto che nel terzo millennio non è ancora del tutto scomparsa una patologia che tanta parte ha avuto nella storia dell’uomo, anche per l’isolamento che in altri tempi colpiva malati considerati inguaribili.
Le stesse considerazioni valgono per la tubercolosi: nonostante la mortalità sia scesa del 40% dal 1990, la malattia rappresenta oggi la seconda causa di morte da malattia infettiva dopo l’Aids. Nel 2012 le persone colpite sono state 8,6 milioni, 1,3 milioni i morti. In Italia nel 2008 sono stati registrati 4.418 casi e di questi il 73% in Lombardia, Lazio, Veneto, Emilia-Romagna e Piemonte. Sebbene il trend sia in generale diminuzione e l’obiettivo dell’Oms sia di eradicare la tubercolosi entro il 2015, come si legge nel Global Plan to Stop TB 2011–2015, negli ultimi anni si registra un lieve rialzo con un lento e progressivo aumento della tubercolosi farmacoresistente. Al punto che negli Stati europei dell’Oms è stato avviato un progetto per prevenire e curare la malattia.
Infine il colera: nel 2012 l’Oms ha riportato 245.393 casi di cui quasi la metà in America. Ed è di questi giorni la segnalazione in Messico di 176 nuovi casi, solo dall’inizio di settembre. Qui ad aumentare il rischio di contagio sono stati l’uragano e il ciclone tropicale che si sono abbattuti sul Paese nella seconda settimana di settembre. Si tratta della prima trasmissione locale di colera dall’epidemia del 1991-2001 e il batterio è simile al 95% a quello che attualmente sta circolando anche ad Haiti, Repubblica dominicana e Cuba. Il Ministero sta affrontando l’emergenza sanitaria garantendo l’accesso all’acqua potabile e ai servizi igienici di base e con campagne di sensibilizzazione.
“Patologie di questo tipo – dice Sgarabotto – sono dovute principalmente alla mancanza di adeguati servizi igienico-sanitari”. Il livello di ricchezza di uno Stato e un sistema sanitario organizzato hanno un ruolo importante nel proteggere da queste infezioni. “Nei casi in cui queste malattie si manifestano nei nostri Paesi – continua – si tratta in larga parte di un fenomeno di importazione legato ai flussi migratori”. E non va trascurato poi che la vaccinazione può incontrare ostacoli di tipo culturale. “È proprio di qualche settimana fa in Pakistan l’attentato contro un gruppo di medici che stava conducendo una campagna di vaccinazione contro la poliomielite”. In quel caso i talebani accusarono gli operatori sanitari di essere spie americane. “Il vaccino è una prassi occidentale che non sempre viene accettata così facilmente, ragion per cui si ritiene preferibile che a condurla sia personale del posto”.
Monica Panetto









